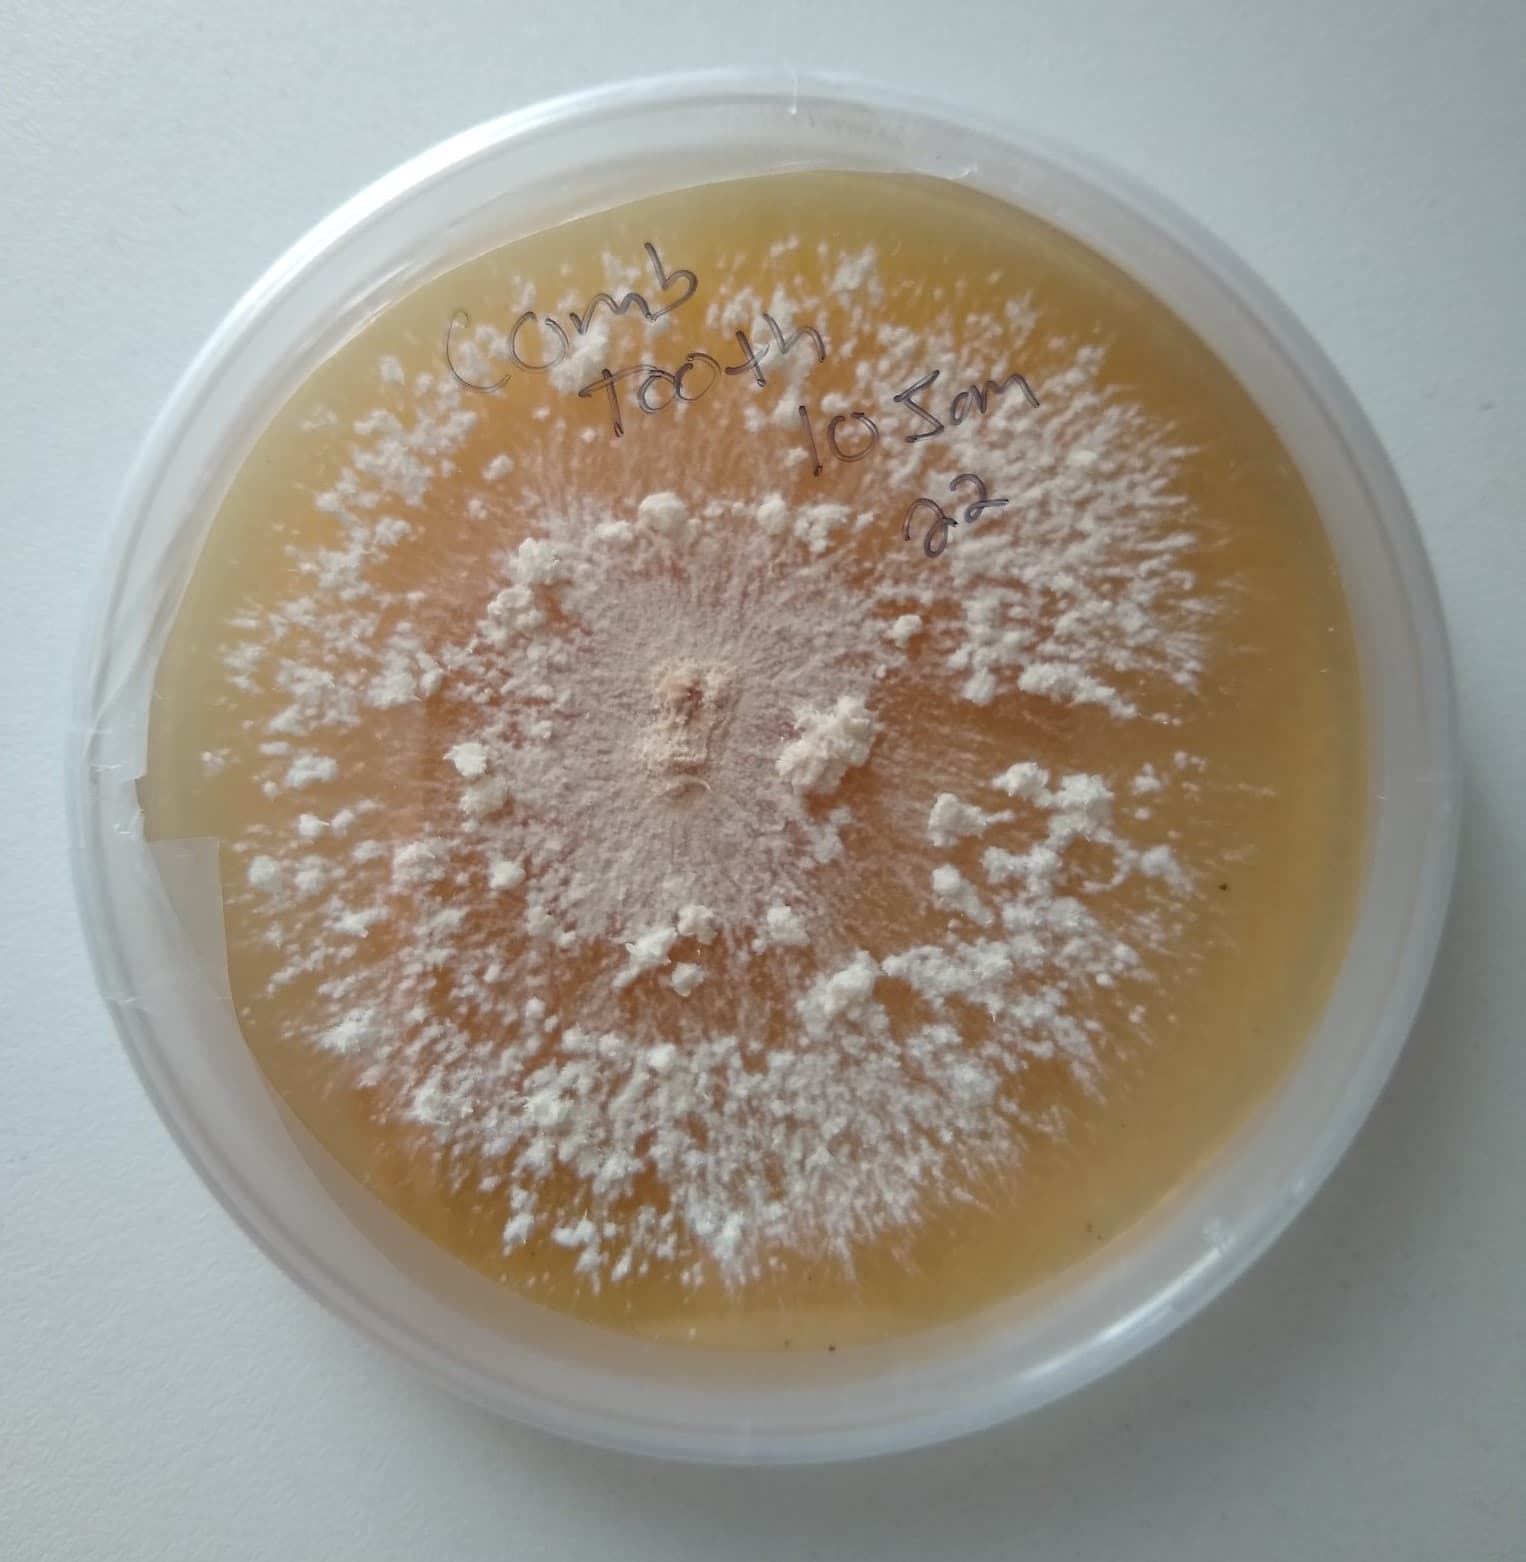

Fungi
Fungi are some of the most interesting organisms on the planet. From the yeasts that ferment our beer and rise our bread, to the strange underground networks of mycelium that give birth to an incredible array of mushrooms, it’s easy to see why our fungal friends are steeped in lore, mystery, and wonder. Our work with mushrooms began long ago, when an interest in cancer medicines and a passion for the natural world combined together in a path of discovery that is still ongoing today. Working with these powerful mushrooms spawned a lifelong obsession with the study of mycelium, mushrooms, and cultivation techniques.
Today, our humble farm has hundreds of cultures of unique and interesting mushroom strains in it’s library, many of them collected from wild specimens right here in Maine. Everything we produce starts from pure mycelium isolated in our laboratory. We generate mother cultures, grain spawn, and fruiting blocks in house to produce all the mushrooms we grow. This helps us maintain a consistent quality, and allows us to produce many species and varieties not widely available commercially.
We offer an assortment of fresh and dried gourmet and medicinal mushrooms for local sale through a number of local health food stores and grocers. We provide cultures for other cultivators and ready-to-fruit hardwood sawdust blocks for anyone who wants to try their hand at growing their own. We sell inoculated logs for shiitake and lion’s mane seasonally, direct from the farm.
We have a significant capacity for fruiting block production and are available for contract production for other farms with wholesale order.